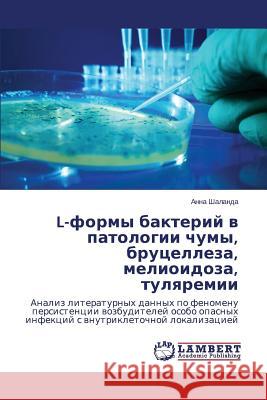
L-formy bakteriy v patologii chumy, brutselleza, melioidoza, tulyaremii Shalanda Anna 9783659572326 LAP Lambert Academic Publishing - książka

L-formy bakteriy v patologii chumy, brutselleza, melioidoza, tulyaremii » książka
L-formy bakteriy v patologii chumy, brutselleza, melioidoza, tulyaremii
ISBN-13: 9783659572326 / Rosyjski / Miękka / 2014 / 72 str.
Uspekhi poslednikh desyatiletiy v oblasti mikrobiologii pokazali, chto nashi prezhnie predstavleniya o vozbuditelyakh zabolevaniy, formakh ikh sushchestvovaniya v prirode, ikh etiologicheskoy, patogeneticheskoy i epidemiologicheskoy roli byli nepolnymi, odnostoronnimi i ne otrazhali vsey sushchnosti yavleniy, imeyushchikh mesto v epidemicheskikh (epizooticheskikh) i infektsionnykh protsessakh. V svyazi s etim v nastoyashchee vremya vedetsya aktivnoe i shirokoe issledovanie etiologii, patogeneza, immunologii, mikrobiologicheskoy diagnostiki, epidemiologii, terapii i profilaktiki zabolevaniy, svyazannykh s neobychnymi infektsionnymi agentami. Svoeobraznym proyavleniem izmenchivosti mikrobov yavlyaetsya fenomen L-transformatsii, morfologicheski proyavlyayushchiysya v formirovanii tak nazyvaemykh L-form. V knige sistematizirovany i obobshcheny literaturnye dannye o roli L-form bakteriy v patologii chumy, brutselleza, melioidoza. Vydvinuta gipoteza o L-variantakh tulyaremiynogo mikroba kak vozmozhnom mekhanizme persistentsii i formirovaniya bessimptomnoy (inapparantnoy) tulyaremiynoy infektsii.
Uspekhi poslednikh desyatiletiy v oblasti mikrobiologii pokazali, chto nashi prezhnie predstavleniya o vozbuditelyakh zabolevaniy, formakh ikh sushchestvovaniya v prirode, ikh etiologicheskoy, patogeneticheskoy i epidemiologicheskoy roli byli nepolnymi, odnostoronnimi i ne otrazhali vsey sushchnosti yavleniy, imeyushchikh mesto v epidemicheskikh (epizooticheskikh) i infektsionnykh protsessakh. V svyazi s etim v nastoyashchee vremya vedetsya aktivnoe i shirokoe issledovanie etiologii, patogeneza, immunologii, mikrobiologicheskoy diagnostiki, epidemiologii, terapii i profilaktiki zabolevaniy, svyazannykh s neobychnymi infektsionnymi agentami. Svoeobraznym proyavleniem izmenchivosti mikrobov yavlyaetsya fenomen L-transformatsii, morfologicheski proyavlyayushchiysya v formirovanii tak nazyvaemykh L-form. V knige sistematizirovany i obobshcheny literaturnye dannye o roli L-form bakteriy v patologii chumy, brutselleza, melioidoza. Vydvinuta gipoteza o L-variantakh tulyaremiynogo mikroba kak vozmozhnom mekhanizme persistentsii i formirovaniya bessimptomnoy (inapparantnoy) tulyaremiynoy infektsii.